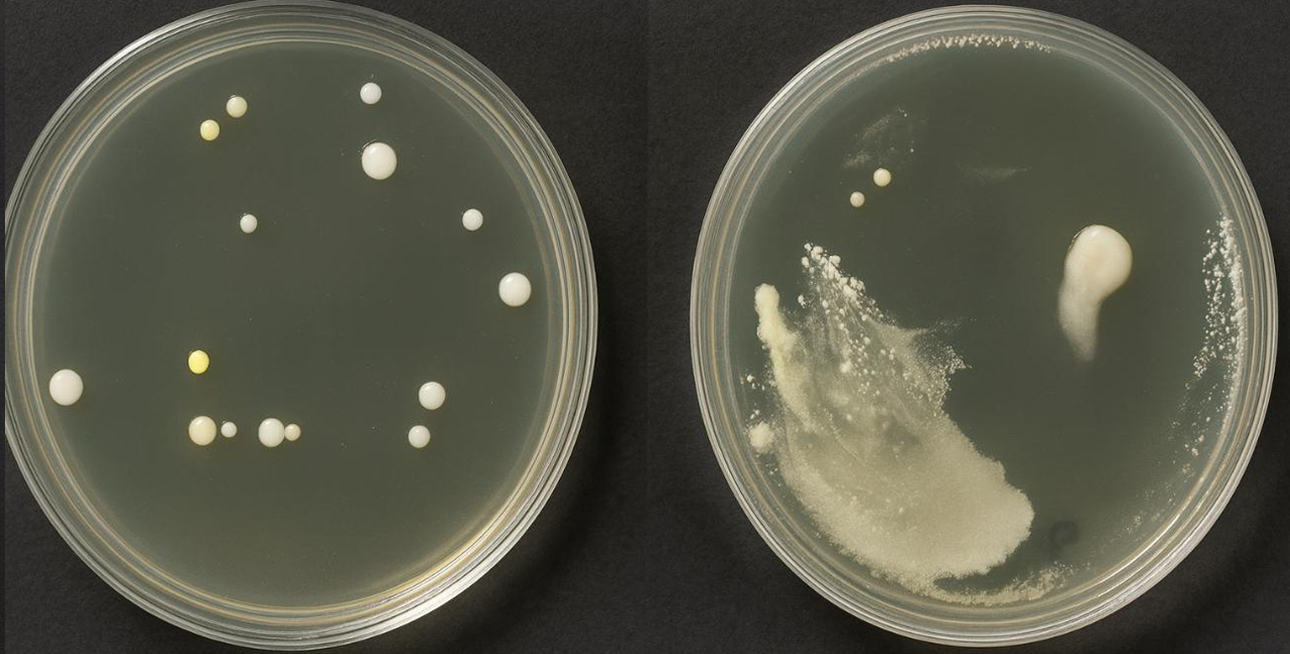
bacterial-fungal-3
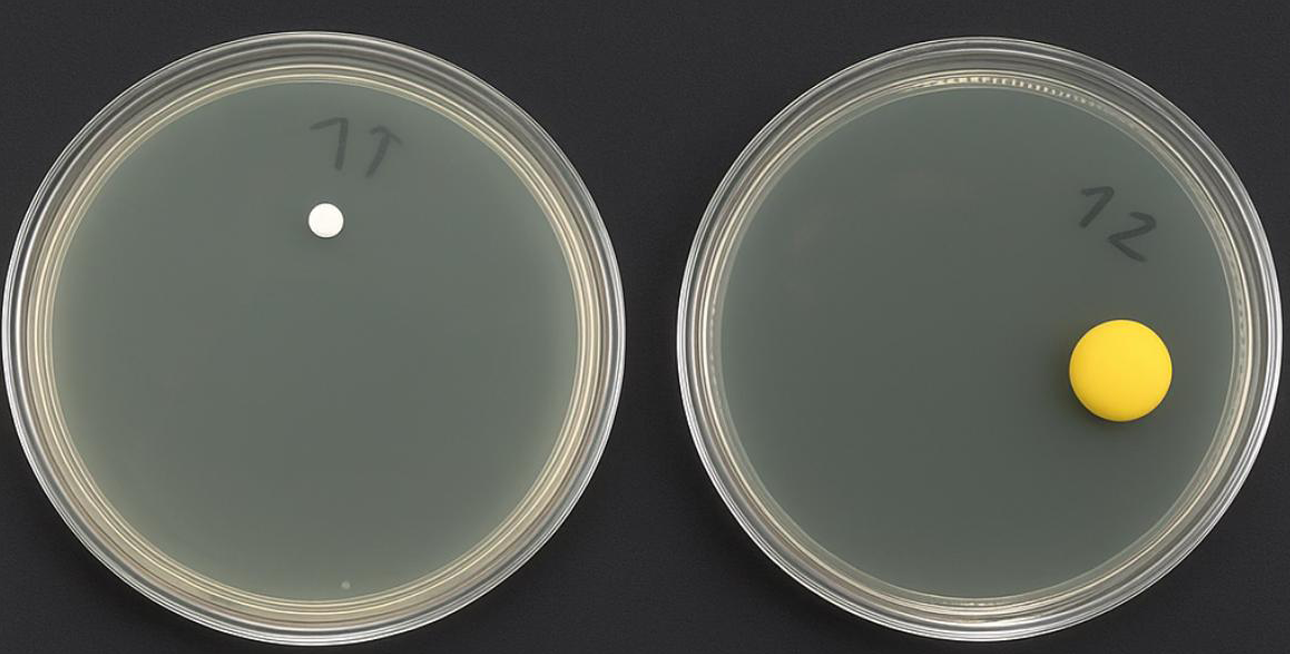
with-wynnshield-3
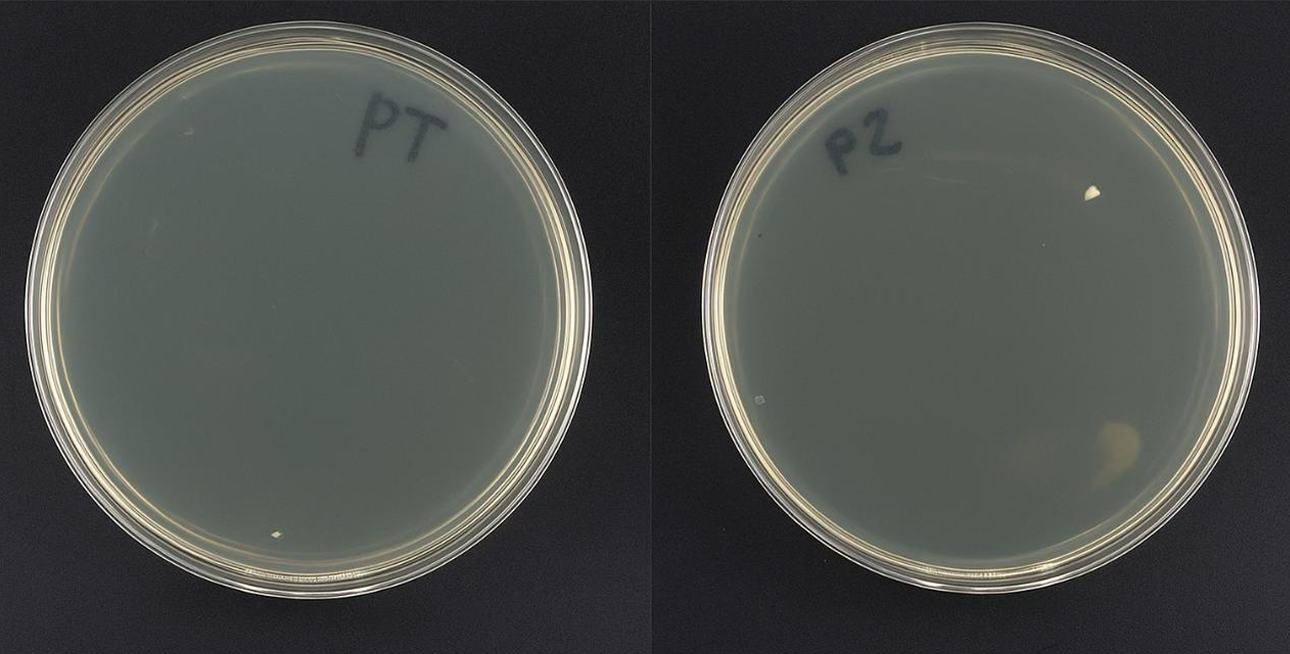
with-wynnshield-1

What is WynnShield™?
Our Products
Without WynnShield
Bacterial & Fungal

With WynnShield
Bacterial & Fungal

How It Works
Benefits

Antimicrobial Product Protection
Wynnshield™ keeps its surface 99.9% cleaner than untreated surfaces. (Claims based on test method ISO 22196)

Device Protection
It serves as a physical barrier, protecting devices from scratches, dings, and other damage that can occur in demanding environments.

Covers Existing Filth and Bacteria
When applied, the WynnShield™ covers any existing filth and bacteria that already existed on the mobile device.

Compatibility and Ease of Use
Designed to be compatible with a wide range of mobile devices, its application process is simple and straightforward, allowing for quick and hassle-free installation.
Product Protection That Lasts™
What Is The Problem?
Frequent Handling
You touch your mobile device numerous times throughout the day, potentially transferring bacteria and filth from your hands onto the device.
Various Environments
Your mobile device comes into contact with different surfaces and environments, some of which may harbor bacteria and filth.
Warmth and Moisture
Mobile devices provide a warm and sometimes moist environment, which can promote bacterial growth.
Rare Cleaning
Many people don’t clean their mobile devices regularly, allowing bacteria and filth to accumulate over time.
Wrap It Up with WynnShield™
Did you know?

Mobile devices can harbor an average of 25,127 bacteria per square inch.

Bacteria can reproduce every 20 minutes on warm, hard surfaces like mobile devices.

Bacteria can survive on hard surfaces for weeks.

Mobile devices are non-porous; allowing bacteria to grow on the surface.
Product Features

Embedded Antimicrobials
Are antimicrobial treatments that are incorporated into polymer-based substrates to inhibit product damaging bacteria growth.
Embedded Antimicrobials
Are antimicrobial treatments that are incorporated into polymer-based substrates to inhibit product damaging bacteria growth.
Protects Your Phone Case

Protects Your Phone Case

Durability
Durability
Water-Resistant And Dust Protection

Water-Resistant And Dust Protection

Built-In Antimicrobial Product Protection.
Microban® Antimicrobial Technology is designed to offer continuous antimicrobial product protection and odor-control through the useful lifetime of the WynnShield™. Microban® product protection initiates upon contact with WynnShield™’s surface, immediately targeting growth of microorganisms responsible for product degradation. This antimicrobial defense operates continuously, ensuring a consistently lower microbial growth compared to products lacking Microban® antimicrobial protection. This ensures that the WynnShield™ remains cleaner and more durable than untreated products.
How It Works

Full Integration
Microban® antimicrobial technology is integrated during the manufacturing process and becomes a permanent structure of WynnShield™’s protective wrap and will not wash off or wear away.

Product Protection
Helps prevent growth of stain and odor-causing bacteria. Product damaging bacteria can double every 20 minutes.

Technology at Work
The antimicrobial technology penetrates the bacteria and inhibits their ability to grow and reproduce.

A Cleaner Mobile Device Wrap
Ultimately the treated surface of the WynnShield™ stays 99.9% cleaner than an untreated surface. (Claims based on test method ISO 22196)



Product Protection That Lasts™
How to Apply WynnShield™

Step 1
Step 2
Step 3
Step 4
Industries / Applications
Healthcare
Food Service
Manufacturing and Industrial
Exposure to hazardous materials, chemicals, and dirty environments.
People need a protective barrier for their mobile devices in manufacturing and industrial settings because these environments often involve exposure to harsh conditions such as dust, chemicals, oils, and heavy machinery. These contaminants can accumulate on mobile devices, posing hygiene risks and potentially damaging the devices. A protective barrier like WynnShield™ offers continuous antimicrobial product protection, reducing damaging bacterial growth on its surface when wrapped around mobile devices. It also offers a durable shield against physical contaminants, ensuring that devices remain functional and easy to use in demanding industrial conditions.
Education
Frequent contact with multiple surfaces and individuals.
A protective barrier like WynnShield™ offers continuous antimicrobial protection, reducing bacterial growth on its surface when wrapped around mobile devices, ensuring devices remain cleaner throughout the school day.
Beach and Pool
High risk of water damage, sand from the beach can get inside devices.
People need a protective barrier for their mobile devices at the beach and pool because these environments expose devices to sand, water, and bacteria. Sand and water can cause physical damage to devices. A protective barrier like WynnShield™ offers continuous antimicrobial device protection, reducing damaging bacterial growth on its surface when wrapped around mobile devices, and offering a layer of defense against potential damage from sand and water. This ensures a protected device experience in these recreational settings.
Transportation
Regular exposure to public surfaces and high-touch areas.
People need a protective barrier for their mobile devices in transportation (airports, city buses, subways etc) because these environments are high-traffic areas where surfaces are touched by many people, increasing the risk of bacterial growth. Mobile devices frequently come into contact with these surfaces, leading to the accumulation of harmful bacteria. A protective barrier like WynnShield™ offers continuous antimicrobial protection, reducing bacterial growth on its surface when wrapped around mobile devices, promoting cleaner devices for travelers.
Retail
Handling cash, products, and interacting with numerous customers daily. Merchants that utilize mobile devices for customers to touch and make payments.
People in retail need a protective barrier for their mobile devices because these devices are frequently used and exposed to high-touch surfaces, customer interactions, and various products. A protective barrier like WynnShield™ also offers continuous antimicrobial product protection, reducing damaging bacterial growth on its surface when wrapped around mobile devices and supporting overall cleaner shared devices in a busy retail environment.
Law Enforcement and Emergency Services
High exposure to various environments and individuals, requiring stringent protocols.
People in law enforcement and emergency services need a protective barrier for their mobile devices due to their constant exposure to various environments and situations that can introduce product damaging bacteria. Mobile devices used in these fields often come into contact with multiple surfaces, bodily fluids, and other hazardous materials. A protective barrier like WynnShield™ offers continuous antimicrobial protection, reducing damaging bacterial growth on its surface when wrapped around mobile devices, ensuring the device remains clean, functional, and supporting cleaner environments in high-risk situations.
Cleaning and Janitorial Services
Regular contact with dirty surfaces and cleaning agents.
People in cleaning and janitorial services need a protective barrier for their mobile devices due to constant exposure to various cleaning agents, chemicals, and dirty environments. These factors can lead to the buildup of bacteria and other contaminants on devices. A protective barrier like WynnShield™ offers continuous antimicrobial product protection, reducing bacterial growth on its surface when wrapped around mobile devices protecting the device from potential damage caused by harsh cleaning chemicals. This ensures the devices remain clean, functional, and enhancing overall workplace cleaning protocols.
Construction
Dust, dirt, and exposure to potentially harmful materials and environments.
People need a protective barrier for their mobile devices in construction due to the harsh conditions these devices are exposed to. Construction sites are filled with dust, dirt, moisture, and various chemicals that can damage electronics. A protective barrier like WynnShield™ offers continuous antimicrobial product protection, reducing damaging bacterial growth on its surface when wrapped around mobile devices, shielding them from physical and environmental hazards, ensuring they remain functional and cleaner throughout the workday.
Laboratories
Handling of hazardous materials.
People need a protective barrier for their mobile devices in laboratories because these environments often involve handling hazardous substances. A protective barrier like WynnShield™ also offers continuous antimicrobial product protection, reducing damaging bacterial growth on its surface when wrapped around mobile devices, thereby maintaining cleaner devices in a laboratory environment.
Outdoor Recreation
People need a protective barrier for their mobile devices during outdoor recreation because these environments expose devices to various contaminants like dirt, dust, sweat, and bacteria. Activities such as hiking, camping, or sports can cause devices to come into contact with unclean surfaces and hands that might not be washed frequently. A protective barrier like WynnShield™ offers continuous antimicrobial product protection, reducing damaging bacterial growth on its surface when wrapped around mobile devices, reducing the buildup of product damaging bacteria, and keeping devices cleaner and device longevity.
Gyms
People need a protective barrier for their mobile devices in gyms because gyms are environments where devices frequently come into contact with bacteria and sweat. Mobile devices can be exposed to bacteria on gym equipment, gym floors, locker room surfaces, and from hands that may not be washed regularly during workouts. A protective barrier like WynnShield™ offers continuous antimicrobial product protection, reducing damaging bacterial growth on its surface when wrapped around mobile devices.
By using protective barriers like WynnShield™, these industries can ensure a cleaner device.
Protection you’ve always needed
Frequently Asked Question
Frequently asked questions about the WynnShield™, addressing common inquiries regarding:
- Compatibility with different devices.
- Longevity of antimicrobial protection.
Connect With Us
What is WynnShield™?
How does Microban® antimicrobial protection work on my WynnShield™?
How long does Microban® product protection last?
Can I charge it?
What is the definition of antimicrobial?
What types of bacteria does Microban® protection work against?
What size mobile devices does it fit?
Is it water resistant?
Is it possible to wipe off or remove the Antimicrobial feature?
What are embedded Antimicrobials?
How quickly does the Microban® technology work?
Can the Antimicrobial agents be transferred to other surfaces?
Can you use a WynnShield™ more than once?
Can I take pictures with WynnShield™ on?
Can I wear my gloves and use my device?
Can I wipe off my device when the WynnShield™ is on?
Will the WynnShield™ muffle sound if my speaker is positioned lower on the screen?
Can I use speakerphone while using WynnShield™?
Wynn Shield is proudly powered by WordPress